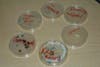

Schools
For Burgers, Not All Mold is Created Equally
That's what one project showed at Harbor Montessori's annual Elementary Exhibition, where kids displayed what they'd learned about science and Asian countries.
Samantha Schreiner said she was inspired by a Big Mac she found at her home. It had been there for two years and three months.Â
Samantha, who attends , was one of more than 50 students who proudly showcased their creative projects as part of the annual Elementary Exhibition on June 9. Every year, the school hosts an open house, inviting friends and family for a night of education and fun. (Click through the photo gallery to learn more about the individual projects.)
Students in first, second and third grades put on a short play and later worked in pairs to make a poster of an Asian country.
Find out what's happening in Gig Harborfor free with the latest updates from Patch.
Fourth, fifth and sixth graders displayed a variety of science projects, including e-portfolios.
"It's a culmination of study that they had been doing for the last two months," said Gail Forecki, who teaches at the school. "We also worked on presentation skills."
Find out what's happening in Gig Harborfor free with the latest updates from Patch.
Forecki said this year's exhibition was another successful turnout.Â
"Kids are eager to learn from each other and through other's projects," she said.
So the question is: Which burger grew the most mold?
"Burger King burger had the most decay," Samantha said while holding a clear container filled with fuzzy gray matter. The Dairy Queen burger, on the other hand, had barely any change.
Nevertheless, no brave volunteer offered to take a bite.
Get more local news delivered straight to your inbox. Sign up for free Patch newsletters and alerts.